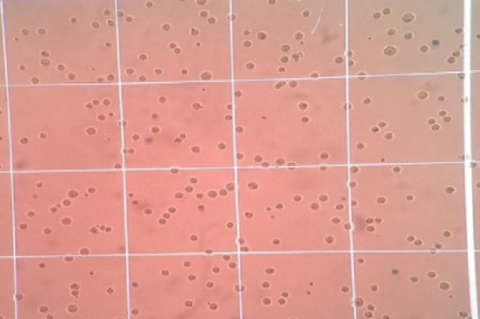
Effect of the extract on mouse DLA cell lines.

Asian Journal of Biological and Life sciences, Vol 12, Issue 3, Sep-Dec, 2023
Recent Articles
Research Article
Effect of Chemical Mutagen on Seed Germination, Morphological and Essential Oil Content in Ocimum basilicum L.
Neha Kumari,Maneesha Singh
Asian J. Biol. Life Sci.,12(3):460-465 DOI: 10.5530/ajbls.2023.12.61 Published: Fri, 16-Feb-2024 Read More
Research Article
Compost Preparation from Different Organic Wastes: Their Biochemical Analysis and Effect on Growth of Bottle Gourd
Tanvi Taneja,Indu Sharma,Mukesh Kumar,Mahesh Kumar Rana,Raj Singh
Asian J. Biol. Life Sci.,12(3):466-472 DOI: 10.5530/ajbls.2023.12.62 Published: Mon, 19-Feb-2024 Read More
Research Article
Molecular Divergence and Phylogenetic Positioning in Siluriformes Species Using mtDNA COI Gene
Mohd Imran
Asian J. Biol. Life Sci.,12(3):473-483 DOI: 10.5530/ajbls.2023.12.63 Published: Mon, 25-Mar-2024 Read More
Research Article
Amelioration of Immune Response Induced Cytokine Imbalance by MERS-CoV Antigen in Gallus gallus domesticus Model by Ethanolic Extract of Nymphaea caerulea
Debasmita Chatterjee,Banhishikha Singh,Krishnendu Paira,Satadal Das
Asian J. Biol. Life Sci.,12(3):484-492 DOI: 10.5530/ajbls.2023.12.64 Published: Mon, 19-Feb-2024 Read More
Research Article
Efficacy of Fungicides and Botanical Extracts against Alternaria brassicicola Causing Leaf Spot of Cabbage (Brassica oleracea var capitata L.)
Sabebaro Namo Das,Pranab Paul,Pranit Saikia
Asian J. Biol. Life Sci.,12(3):493-498 DOI: 10.5530/ajbls.2023.12.65 Published: Mon, 19-Feb-2024 Read More
Research Article
Identification of Bioactive Compounds in Acetone Leaf and Stem-Bark Extracts of Psychotria dalzellii Hook.f. by GC-MS Analysis and Evaluation of in vitro Anti-bacterial Properties
Aralahalli Borappa Thejashree,Raja Naika
Asian J. Biol. Life Sci.,12(3):499-509 DOI: 10.5530/ajbls.2023.12.66 Published: Mon, 19-Feb-2024 Read More
Research Article
Antibacterial Activity of Water Soluble and Fat- Soluble Vitamins against Drug Resistance Clinical Bacteria Klebsiella Pneumonia
Afrah Abdul Kader,Alfiya Azeez,Ayifa Mahjabin,Fairos Babu,Farha Madathil Mikacha,Fathima Shabeena,Fida Fathima,Fidha Sulthana,Hameena Hanna,Hanoona Parambatt,Jumni Ambalavan Peediyakkal,Lafa Shihab,Mohammed Abdul Kareem,Muhammed Nihad,Munawvara Fathima,Nadeena Sherin,Nandhana Dineeshan Sinitha,Nida Sherin,Mohamed Nafees,Ruqaya Mustafa,Shahana Sini,Shahla Thasni,Sreeshna Pallath,Vafeena Mariyam,Abdul Hannan Shaikh,Shilpa V,Sirajudheen Mukriyan Kallungal,Muddukrishnaiah Kotakonda
Asian J. Biol. Life Sci.,12(3):510-515 DOI: 10.5530/ajbls.2023.12.67 Published: Mon, 19-Feb-2024 Read More
Research Article
A Study on Callus Induction and the Successful Regeneration of Plantlets from Rhizome Explants of Alpinia galanga (L.) Willd., a Valuable Medicinal Plant
Kizhakke Modongal Shamsudheen,Valiyaparambath Musfir Mehaboob,Kunnampalli Faizal,Palusamy Raja,Ganesan Thiagu,Appakan Shajahan
Asian J. Biol. Life Sci.,12(3):516-522 DOI: 10.5530/ajbls.2023.12.68 Published: Mon, 19-Feb-2024 Read More
Research Article
Phylogeny Influences Genome Size and GC but not Sequence and Organismal Complexity in Staphylococci
Akash Ajay
Asian J. Biol. Life Sci.,12(3):523-529 DOI: 10.5530/ajbls.2023.12.69 Published: Mon, 19-Feb-2024 Read More
Research Article
Phytochemical Analysis and in vitro Antioxidant Activities of Three Species of Premna L. from Kerala
Harikrishnan M. R,Suhara Beevy
Asian J. Biol. Life Sci.,12(3):530-540 DOI: 10.5530/ajbls.2023.12.70 Published: Mon, 19-Feb-2024 Read More
Research Article
Investigation of Dormancy Breaking and Water Uptake Mechanisms in Majidea zangueberica Kirk ex Oliv., Markhamia lutea (Benth.) K. Schum., Tabebuia aurea (Silva Manso) Benth. and Hook. f. ex S. Moore, Santalum album L., and Morinda citrifolia L. seeds.
Preethi jenifer Praticia
Asian J. Biol. Life Sci.,12(3):541-550 DOI: 10.5530/ajbls.2023.12.71 Published: Mon, 19-Feb-2024 Read More
Research Article
Red Grape Seed Extract (RGSE) declines Neuronal and Oxidative Damage in the Brain Regions of Alzheimer’s Induced Wistar Rats.
M .Thulasi,K. Janardhana,C. Aruna,Muniya Naik,Govardhan Naik,Uday Kiran
Asian J. Biol. Life Sci.,12(3):551-557 DOI: 10.5530/ajbls.2023.12.72 Published: Mon, 19-Feb-2024 Read More
Research Article
Evaluation of in vitro Anti-Inflammatory Activity of Leaves of Terminalia chebula Retz. (Combretaceae)
Soumya Jose,Sreeja Thankappan
Asian J. Biol. Life Sci.,12(3):558-563 DOI: 10.5530/ajbls.2023.12.73 Published: Mon, 19-Feb-2024 Read More
Original Article
Antioxidant Potential, Antidiabetic, and Anti-Inflammatory Activities of White Cowpea (Vigna unguiculata L.): An in vitro Study
Durga Priyadarshini,Annette Beatrice,C. Sivaraj
Asian J. Biol. Life Sci.,12(3):564-573 DOI: 10.5530/ajbls.2023.12.74 Published: Mon, 19-Feb-2024 Read More
Original Article
Antibacterial and Mosquito Repellent Assay of Poly Herbal Oil
R. Marivignesh,M.I. Zahir Hussain,M. Vijayalakshmi,A. Shajahan,Ramesh kumar,Sithi Jameela
Asian J. Biol. Life Sci.,12(3):574-579 DOI: 10.5530/ajbls.2023.12.75 Published: Mon, 19-Feb-2024 Read More
Research Article
Elevated Temperature and Carbon Dioxide alter the Tea Rhizosphere Soil Dynamics
Ajmeri Sultana Rahman,Jayanta Barukial,Satya Ranjan Sarmah,Rupanjali Deb Baruah
Asian J. Biol. Life Sci.,12(3):580-586 DOI: 10.5530/ajbls.2023.12.76 Published: Mon, 19-Feb-2024 Read More
Research Article
Evaluation of Molecular Genetic Diversity and DNA Barcoding of Rita gogra (Family Bagridae) from Narmada River Revealed through Mitochondrial COX1 Gene Sequencing
R. K. Garg,Surbhi Dohre
Asian J. Biol. Life Sci.,12(3):587-595 DOI: 10.5530/ajbls.2023.12.77 Published: Tue, 20-Feb-2024 Read More
Research Article
In vitro Anti-Cancer Activity of Plectranthus amboinicus (Lour.) Spreng. in DLA Cell lines
Jithesh Krishnan R,Asha Ramachandran,Abhilash Sivadasan
Asian J. Biol. Life Sci.,12(3):596-602 DOI: 10.5530/ajbls.2023.12.78 Published: Mon, 19-Feb-2024 Read More
Original Article
Effect of Alpha-Phellandrene on Glucose Uptake and Adipogenesis in Insulin Resistant 3T3-L1 Adipocytes: an in vitro and in silico Approach
Souprayen Seethalakshmi,Ravishankar Sarumathi,Chandrasekaran Sankaranarayanan
Asian J. Biol. Life Sci.,12(3):603-610 DOI: 10.5530/ajbls.2023.12.79 Published: Mon, 19-Feb-2024 Read More
Research Article
Exploring the Anti-Inflammatory Effects of Aprepitant: An Antagonist of the Neurokinin-1 Receptor
Pavithra J,Shila G,Maheshwaran P,John Staines M,Sakthi Sundaram S
Asian J. Biol. Life Sci.,12(3):611-615 DOI: 10.5530/ajbls.2023.12.80 Published: Mon, 19-Feb-2024 Read More
Research Article
Comparative Hematological Profile of Three Species of Schizothorax Group Found in the Streams of Himalayan Region
Siddiqui U,Rani A,Bisht H.C.S,Pandey N.N
Asian J. Biol. Life Sci.,12(3):616-621 DOI: 10.5530/ajbls.2023.12.81 Published: Mon, 19-Feb-2024 Read More
Research Article
Isolation of Lactobacilli from Freshly Drawn Raw Milk of Desi and Crossbred Cows of Gurugram Region, Haryana
Mukul Mudgal,Sandhya Khunger,Sunil Kumar,Mukesh Sharma
Asian J. Biol. Life Sci.,12(3):622-627 DOI: 10.5530/ajbls.2023.12.82 Published: Mon, 19-Feb-2024 Read More
Research Article